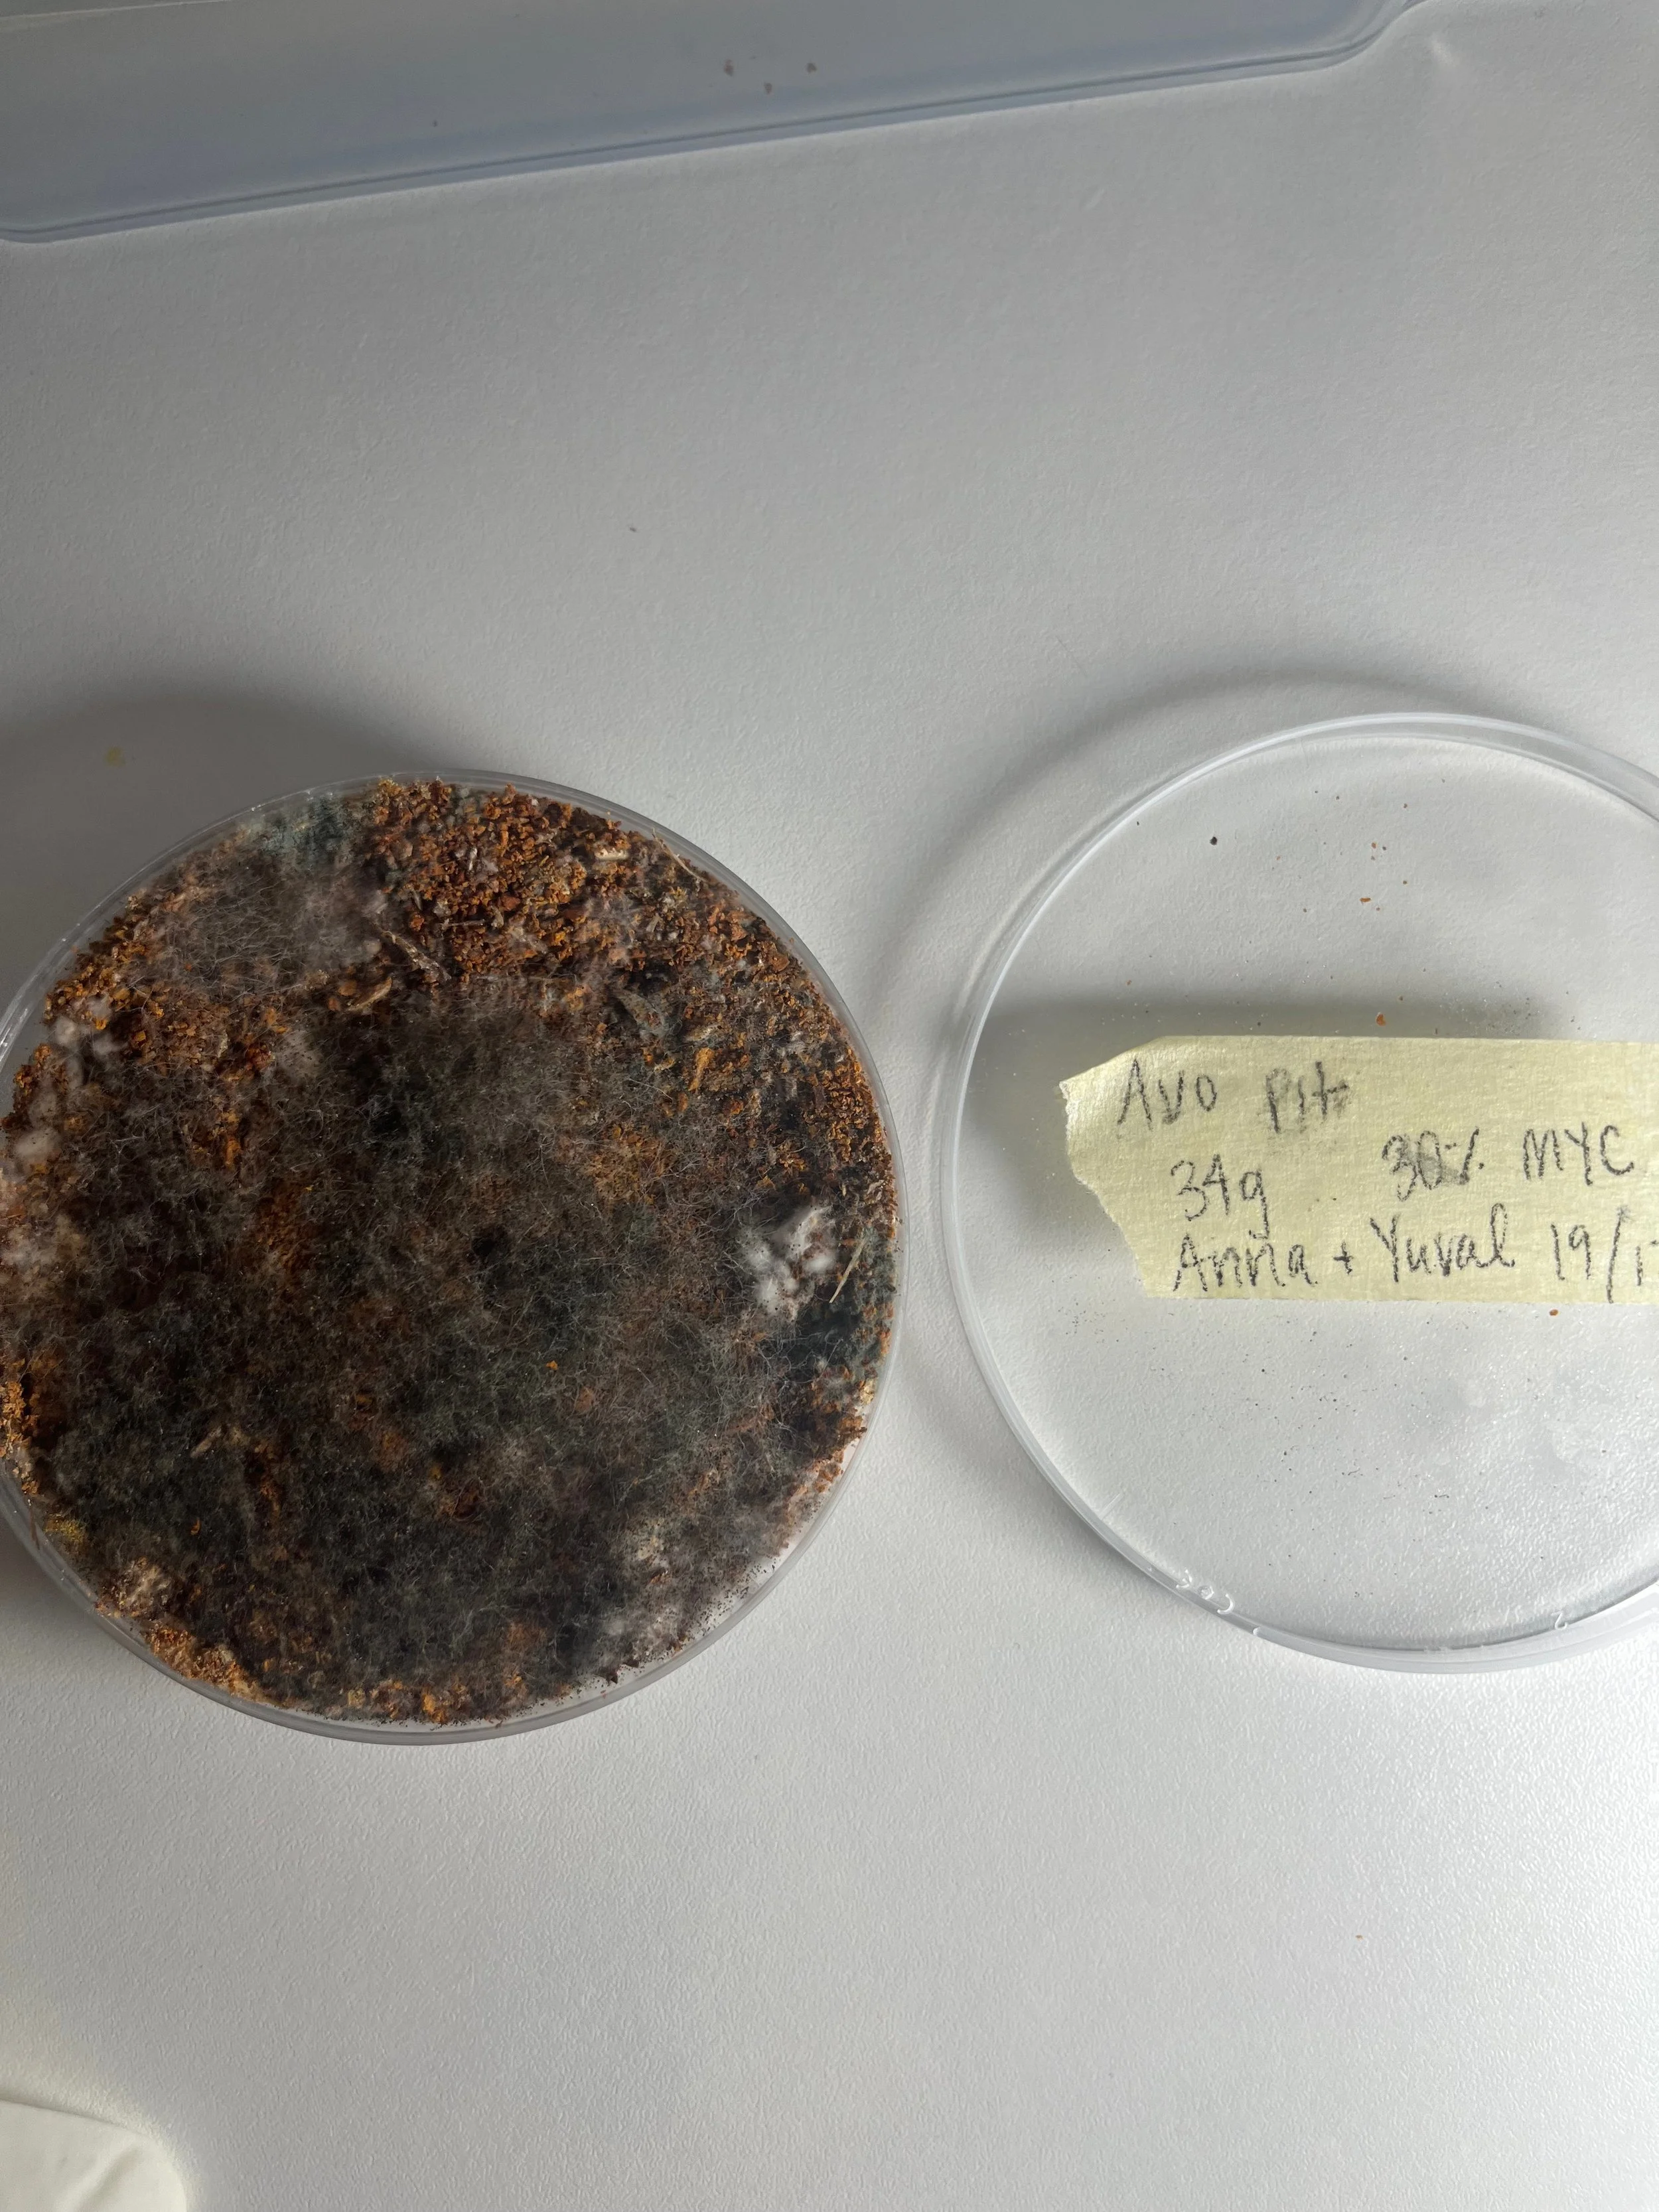

Mycelium tamagotchi






Mycelium tamagotchi